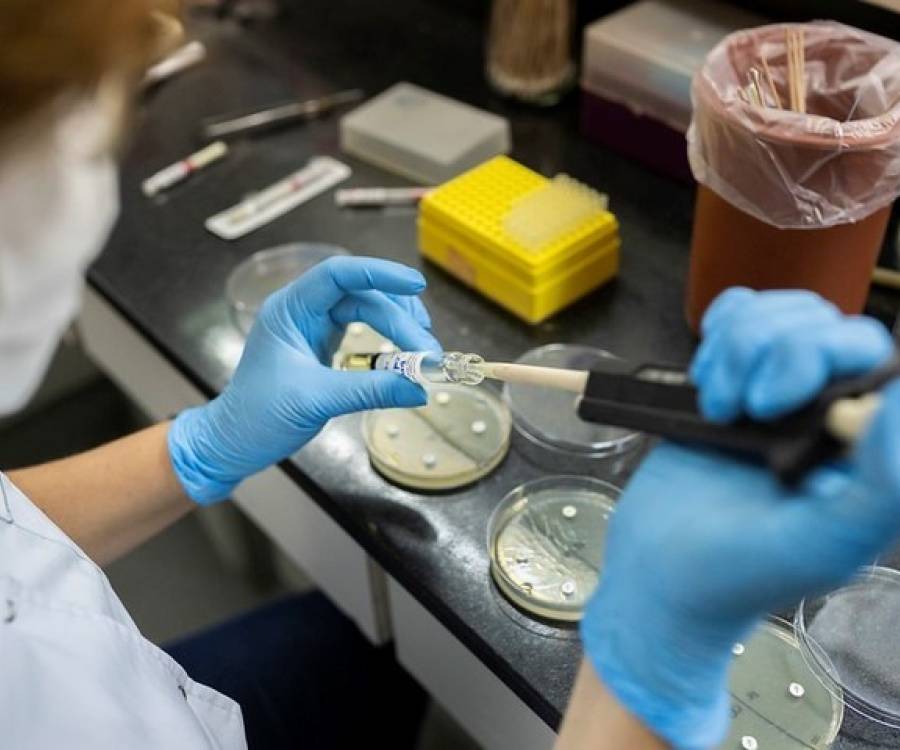
La gripe H3N2 avanza en Argentina y ya investigan como frenarla

El Ministerio de Capital Humano iniciará el 6 de enero un plan piloto que apunta a transformar los programas sociales en formación profesional. La iniciativa tendrá alcance nacional y podría impactar también en provincias como Catamarca, donde miles de beneficiarios integran el esquema actual.
El Gobierno nacional pondrá en marcha el próximo 6 de enero un plan piloto destinado a reconvertir los planes sociales en programas de capacitación laboral, con el objetivo de reducir la asistencia directa y promover la inserción en el mercado de trabajo. La iniciativa es impulsada por el Ministerio de Capital Humano y forma parte de una reforma más amplia del sistema de ayuda social.
La propuesta apunta a que más de 900.000 beneficiarios del programa Volver al Trabajo (VAT), que actualmente perciben un ingreso mensual de $78.000, pasen progresivamente a recibir vouchers educativos. Si bien el esquema ya se encuentra habilitado, el 6 de enero se realizará la primera prueba piloto.
En paralelo, desde la cartera que conduce Sandra Pettovello evalúan unificar distintas asignaciones —como la Asignación Universal por Hijo (AUH), la asignación por embarazo, el Plan Mil Días y la Tarjeta Alimentar— en una AUH Familiar. Además, avanzan en el desarrollo del Sistema Integrado de Información Social (SIIS), que permitirá conocer con mayor precisión cuántas prestaciones recibe cada hogar.
Para este proceso, la Secretaría de Innovación trabaja en la creación de una nube que alojará datos sensibles cruzados entre el Ministerio de Capital Humano y organismos como ANSES, Renaper, ARCA, el Ministerio de Salud y la Secretaría de Energía.
Entre los principales componentes del nuevo sistema se destacan el Registro Único de Beneficiarios (RUB), que conformará una base de datos centralizada inédita hasta el momento, y el Registro Social de Hogares (RSH), diseñado para identificar necesidades específicas en situaciones excepcionales.
Cómo será el plan piloto de reconversión de planes sociales
En esta primera etapa, Capital Humano seleccionará a 20 beneficiarios del programa Volver al Trabajo para cursar dos módulos de ocho clases durante un período de dos meses. Al finalizar, los participantes obtendrán un título profesional en pintura de obra. En esta fase inicial, no se prevé que dejen de percibir su haber.
Los cursos, que incluirán contenidos teóricos y prácticos, así como la provisión de materiales de pintura y estudio, estarán a cargo de la empresa Sinteplast, una de las primeras en sumarse al proyecto. Para acceder al título, los alumnos deberán cumplir con al menos el 70% de asistencia.
La capacitación se dictará en el Centro de Formación Capital Humano, ubicado en el Predio Garrigós, en el barrio porteño de La Paternal, que fue restaurado y puesto en valor desde marzo con el apoyo de la Bolsa de Comercio.
Desde el equipo de Pettovello esperan que la iniciativa, que comenzará en enero, pueda extenderse a municipios y provincias de todo el país, incluida Catamarca.
Durante 2024, el Ministerio de Capital Humano ya avanzó en la reconversión del programa Potenciar Trabajo, que alcanzaba a cerca de 1.300.000 beneficiarios y fue dividido en Volver al Trabajo (VAT) y el Programa de Acompañamiento Social (PAS). En ese marco, también se eliminó la contraprestación laboral con el objetivo de reducir la intermediación de los movimientos sociales.